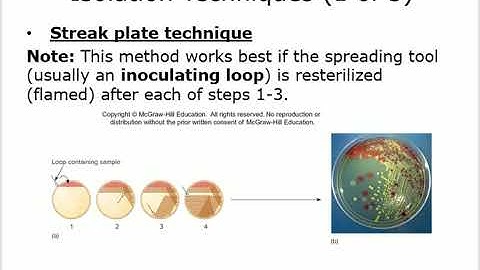
Microbiology Chapter 3 Lab Tools By Dr  Saudi

⬇ DOWNLOAD NOW
Kalau muncul iklan pop-up, tutup lalu klik tombol kembali
Download lagu Chapter 3 – Tools of the Laboratory secara gratis hanya untuk keperluan promosi. Dukung artis favorit kamu dengan membeli musik original di iTunes atau platform resmi lainnya.
 Ch. 3 - Tools of the Laboratory (part 1 of 2)
Ch. 3 - Tools of the Laboratory (part 1 of 2)
 Lecture 3: Tools of the Laboratory--Microbiology with Dr. Crystal A. Morrison
Lecture 3: Tools of the Laboratory--Microbiology with Dr. Crystal A. Morrison
 Lab Tools and Equipment - Know your glassware and become an expert Chemist! | Chemistry
Lab Tools and Equipment - Know your glassware and become an expert Chemist! | Chemistry
Microbiology Chapter 3 Lab Tools By Dr Saudi
Microbiology Chapter 3 Lab Tools By Dr Saudi
 MCB 3020 Lab: Chapter 3 The General Microbiology Lab
MCB 3020 Lab: Chapter 3 The General Microbiology Lab
 BI280 Chapter 3 Tools of Microbiology - Part 2 of 2
BI280 Chapter 3 Tools of Microbiology - Part 2 of 2
 Intro to Biotechnology - Chapter 3, Part 1 - Volume Measurement and Tools
Intro to Biotechnology - Chapter 3, Part 1 - Volume Measurement and Tools
 BI280 Chapter 3 Tools of Microbiology - Part 1 of 2
BI280 Chapter 3 Tools of Microbiology - Part 1 of 2